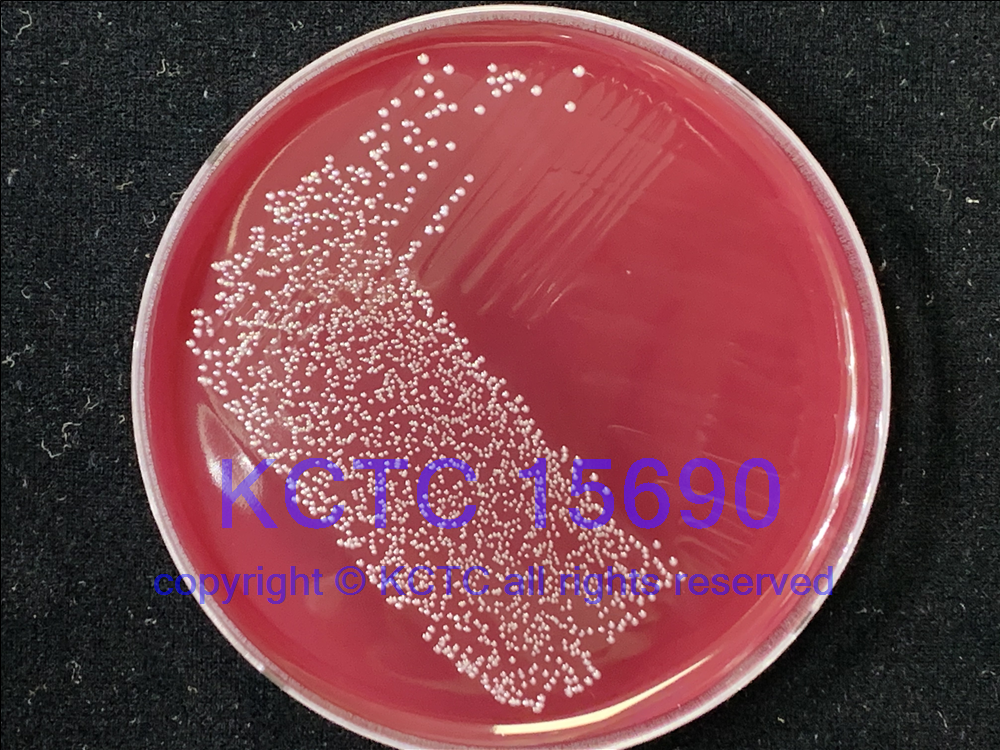

KCTC No. 15690
(KCTC Other No.) = KCTC 5879
Resource Type Bacteria
Name Dorea formicigenerans
Type Strain Yes
Biosafty Level 1
LMO No
Synonym Eubacterium formicigenerans
Phylum (ex Phylum) Bacillota (Firmicutes)
Genome Information
NCBI Genome UID : GCA_025150245.1
JGI Genome ID : Gp0000907
History <- DSM <- ATCC <- LV Holdeman, VPI C8-13
Source From human faeces
Other Collection No. VPI C8-13, ATCC [27755], DSM [3992], JCM [10342], KCTC [5879]
Reference 1 / 10.1099/00207713-30-1-225, 10.1099/00207713-52-2-423
KCTC Media No. KCTC media No. 18 Chopped Meat Medium + [1% glucose]
KCTC media No. 1364 TSA with 5% blood
Oxygen Requirement Anaerobic
Temperature 37 ℃
pH netural pH ?? ?? (???? ??)
Incubation Time 2-3d [???? ???? ????? ??, ?? ? ????? ??? ?? ?? ? ??]
KCTC15690